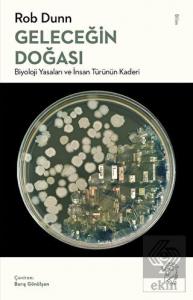
Geleceğin Doğası

Lezzetli yiyeceklerin peşinden gitmenin insanlık tarihinin seyrini nasıl yönlendirdiğine dair iştah açıcı bir anlatı.
Doğanın bizi iştahla yemeye davet ettiği, ödülünü ise lezzet sunarak verdiği söylenir. Peki bir yiyeceği lezzetli kılan ölçütler nelerdir? Neden bazı tatlara bayılırken bazılarından hiç hoşlanmayız? Leziz Lezzetin Evrimi Bizi Nasıl İnsan Yaptı? bu tür soruların merkezine yapılan son derece eğlenceli bir yolculuk.
Rob Dunn ve Monica Sanchez, sıcaklık ve zekâ dolu anlatımlarıyla, yiyeceklerden aldığımız hazzın nedenlerine ve lezzet arayışının insanlık tarihinin seyrini nasıl yönlendirdiğine dair cesur ve yeni bir bakış açısı sunuyor. En güncel bilimsel araştırmaları canlı hikâyelerle birleştirerek, lezzeti hem biyolojik hem de kültürel bir olgu olarak işliyor. Lezzetin ilk aletlerin icadında, dev memelilerin yok oluşunda, dünyanın en lezzetli ve yağlı meyvelerinin evriminde, biranın ortaya çıkışında ve kendi toplumsallığımızın biçimlenmesinde nasıl bir rol oynamış olabileceğini ele alıyor. Bu yolculuk boyunca, belki varlığından bile haberdar olmadığınız tat reseptörlerini, bir mamutu fermente etmenin en iyi yolunu, Paleolitik Çağ sanatı ile peynir arasındaki ilişkiyi ve daha pek çok şaşırtıcı ayrıntıyı öğreneceksiniz.
Bu kitap, insan evrimini yalnızca hayatta kalma mücadelesi üzerinden değil, haz, tat ve arzu üzerinden düşünmeye davet ediyor. Lezzet arayışının ardındaki derin ve şaşırtıcı tarihi gözler önüne seriyor.
Lezzetli yiyeceklerin peşinden gitmenin insanlık tarihinin seyrini nasıl yönlendirdiğine dair iştah açıcı bir anlatı.
Doğanın bizi iştahla yemeye davet ettiği, ödülünü ise lezzet sunarak verdiği söylenir. Peki bir yiyeceği lezzetli kılan ölçütler nelerdir? Neden bazı tatlara bayılırken bazılarından hiç hoşlanmayız? Leziz Lezzetin Evrimi Bizi Nasıl İnsan Yaptı? bu tür soruların merkezine yapılan son derece eğlenceli bir yolculuk.
Rob Dunn ve Monica Sanchez, sıcaklık ve zekâ dolu anlatımlarıyla, yiyeceklerden aldığımız hazzın nedenlerine ve lezzet arayışının insanlık tarihinin seyrini nasıl yönlendirdiğine dair cesur ve yeni bir bakış açısı sunuyor. En güncel bilimsel araştırmaları canlı hikâyelerle birleştirerek, lezzeti hem biyolojik hem de kültürel bir olgu olarak işliyor. Lezzetin ilk aletlerin icadında, dev memelilerin yok oluşunda, dünyanın en lezzetli ve yağlı meyvelerinin evriminde, biranın ortaya çıkışında ve kendi toplumsallığımızın biçimlenmesinde nasıl bir rol oynamış olabileceğini ele alıyor. Bu yolculuk boyunca, belki varlığından bile haberdar olmadığınız tat reseptörlerini, bir mamutu fermente etmenin en iyi yolunu, Paleolitik Çağ sanatı ile peynir arasındaki ilişkiyi ve daha pek çok şaşırtıcı ayrıntıyı öğreneceksiniz.
Bu kitap, insan evrimini yalnızca hayatta kalma mücadelesi üzerinden değil, haz, tat ve arzu üzerinden düşünmeye davet ediyor. Lezzet arayışının ardındaki derin ve şaşırtıcı tarihi gözler önüne seriyor.
| Taksit Sayısı | Taksit tutarı | Genel Toplam |
|---|---|---|
| Tek Çekim | 346,50 | 346,50 |
| 2 | 180,18 | 360,36 |
| 3 | 124,74 | 374,22 |
| Taksit Sayısı | Taksit tutarı | Genel Toplam |
|---|---|---|
| Tek Çekim | 346,50 | 346,50 |
| 2 | 180,18 | 360,36 |
| 3 | 124,74 | 374,22 |